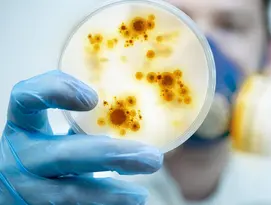

Elis Pest Control
Rodent Control, Insect Control, disinfection: we offer optimal protection for your facility. Because pests represent a threat to the integrity of your premises, the hygiene, as well as the image of your company, we offer a complete prevention and control service by ensuring systematic traceability of all interventions carried out.
The environmental impact is the core of our priorities; we base our interventions on the integrated pest management method based on the adoption of innovative techniques and solutions that are more respectful of the environment.
Moreover, Elis offers a microbial disinfection service that is safe for human health. It allows an adapted treatment of the surfaces and volumes of your premises.
Ask for a quoteDiscover our solution in video
The Elis Pest Control service includes :
-
Audit your site
-
Targeted on-site installation
-
Regular monitoring and follow-up
-
Traceability of all our work
-
Technical advice and recommendations
-
Intervention report sent systematically by e-mail
-
Curative action in the event of infestation
Elis guarantees systematic traceability of interventions

Discover also
If you need information or a quote for your project, our teams are here to help. Contact us!
*Required fields
Account details